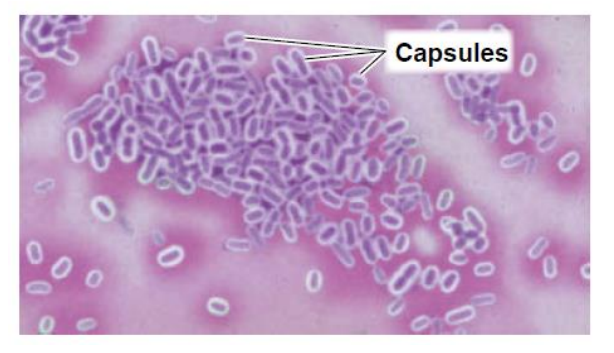
<ul><li><p>capsule - gelatinous covering of many microorganisms</p></li><li><p>presence of capsule = determining the organism’s virulence (degree to which a pathogen can cause disease) </p></li><li><p>more difficult because capsular materials are water soluble</p></li><li><p>capsules do not accept most biological dyes such as safranin = halo </p></li></ul><p></p>

1/47
Staining and Bacterial Growth
Name | Mastery | Learn | Test | Matching | Spaced | Call with Kai |
|---|
No analytics yet
Send a link to your students to track their progress
staining
coloring of microorganisms with dye to emphasize certain structures
stains
salts composed of a positive and negative ion, one of which is colored and is known as a chromophore
chromophore
colored ion in stains
basic dye
the color is in cation
acidic dye
the color is in anion
negative staining
preparing colorless bacteria against a colored background
valuable for observing cell shapes, size, and capsule
halo/capsule can be seen
cells are made highly visible against a contrasting dark background
simple staining
aqueous or alcohol solution of a single basic dye
highlights entire microorganism so the cellular shape and basic structure of cells are visible
mordant
additive used to increase affinity of stain
coat a structure to make it thicker and easier to see
examples of mordant additive
methylene blue - blue in color
carbolfuchsin - red in color
crystal violet - violet/purple in color
safranin - pinkish-red in color
differential stain
reacts with different kinds of bacteria
gram stain and acid-fast stain
gram stain
developed by Hans Christian Gram in 1884
most useful staining procedure
classifies bacteria into 2 large groups: gram-positive and gram-negative
gram reaction can provide valuable information for the treatment of disease
gram-positive = can be killed by penicillin and cephalosporin
gram-negative = generally more resistant due to the lipopolysaccharide layer
process of gram staining
cover the heat-fixed smear with basic purple dye (crystal violet), referred to as primary stain
wash off the purple dye and the smear is covered with iodine, a mordant
wash the slide with alcohol or an alcohol-acetone solution (decolorizing agent) which removes the purple from the cells of some species
the alcohol is rinsed off then stained with safranin, a basic red dye
the smear is washed, blotted dry, and examined microscopically

acid-fast stain
binds strongly only to bacteria that have waxy material in their cell wall
used to identify all bacteria in genus Mycobacterium (M. tuberculosis and M. leprae) and pathogenic strains of Nocardia
process of acid-fast staining
red dye carbolfuchsin is applied to a fixed smear and the slide is gently heated for several minutes
slide is cooled and washed with water
the smear is treated with acid-alcohol (decolorizer) which removed the red stain from bacteria that are not acid-fast
smear is then stained with methylene blue (counter stain)

special stains
used to color parts of the microorganism (endospores flagella, or capsules)
negative staining for capsules
capsule - gelatinous covering of many microorganisms
presence of capsule = determining the organism’s virulence (degree to which a pathogen can cause disease)
more difficult because capsular materials are water soluble
capsules do not accept most biological dyes such as safranin = halo
process of staining for capsules
mix the bacteria in a solution containing fine colloidal suspension of colored particles (India ink or nigrosine) for contrasting background
stain the bacteria with simple stains such as safranin
endospore staining
endospore - a special resistant, dormant structure formed within a cell that protects a bacterium from adverse environmental conditions
endospores cannot be stained by ordinary methods because they don’t penetrate the endospore’s wall
endospores appear green within red or pink cells

Schaeffer-Fulton endospore stain
most commonly used for endospore staining
process of endospore staining
malachite green is applied to a heat-fixed smear and heated to steaming for 5 minutes
the preparation is washed for about 30 seconds with water
safranin is applied to the smear stain proportions of the cell other than endospores
flagella staining
flagella - structures for locomotion too small to be seen
uses mordant and the stain carbolfuchsin to build up the diameters of the flagella

requirements for bacterial growth
physical
temperature
pH
osmotic pressure
chemical
carbon
nitrogen
sulfur
phosphorus
oxygen
Temperature
certain bacteria are capable of growing at extremes of temperature that would certainly hinder the survival of almost all eukaryotic organisms

psychrophiles
cold-loving microbes
organisms capable of growing at 0 degrees Celsius
most of these organisms are so sensitive to higher temperature that they cannot grow in a warm room (25 degrees)
found mostly in the ocean’s depth or polar regions (seldom problems in food preservation)
psychrotrophs
organisms that can grow at 0 degrees but optimum growth temp is 20-30 degrees and cannot grow above 40 degrees
mostly encountered in low-temperature food spoilage because they can grow at refrigerator temperatures
spoilage organisms
mesophiles
moderate-temperature-loving microbes)
the most common type of microbe
optimum temperature for any pathogenic bacteria is about 37 degrees
includes most of the common spoilage and disease organism
thermophiles
heat-loving microbes
microorganisms capable of growth at high temperatures
optimum growth: 50-60 degrees
not considered a public health concern
important in organic compost piles
hyperthermophiles or extreme thermophiles
microbes that have an optimum growth temperature of 80 degrees
pH
most bacteria grow best in a narrow pH range near neutrality (between 6.5 and 7.5)
very few bacteria grow at an acidic pH below about pH4
acidophiles
microorganisms that are tolerant of acidity
osmotic pressure
most organisms must be grown in a medium that is nearly all water (1.5% concentration of agar)
if osmotic pressure is low (environment is hypotonic), microbes with weak cell wall may be lysed
halophiles
can adapt to high salt concentrations
chemical requirement
carbon
trace elements (iron, copper, molybdenum, and zinc)
oxygen
obligate aerobes
facultative anaerobes
aerotolerant anaerobes
microaerophiles
obligate aerobes
organisms that require oxygen to live

facultative anaerobes
can use oxygen when it is present but are able to continue growth by using fermentation or anaerobic respiration when oxygen is not available
ex. E.coli

anaerobes
bacteria that are unable to use molecular oxygen for energy yielding reactions
ex. Clostridium

aerotolerant anaerobes
fermentative and cannot use oxygen for growth, but they tolerate it fairly well

microaerophiles
aerobic; they do not require oxygen
they grow inly in oxygen concentrations lower than those in air

bacterial growth
refers to an increase in bacterial numbers, not an increase in the size of individual cells
bacteria reproduce the binary fission
few bacterial reproduce by budding
budding
forming a small initial outgrowth that enlarges until its size approaches that of the parent cell, then it separates
binary fission
asexual reproduction
cell elongates and DNA is replicated
plasma membrane begins to constrict and a new wall is made
cross-wall forms, completely separating the two DNA copies
cells separate

generation time
time required for a cell to divide
varies considerably among organisms and with environmental conditions such as temperature
uses logarithmic scales

phases of growth
lag phase
log phase
stationary phase
death phase
lag phase
preparing for population growth, but no increase in population
a period of little to no cell division
can last for 1 hour or several days
cells are not dormant
period of intense metabolic activity such as synthesis of enzymes
incubation period
log phase
logarithmic or exponential increase in population
cell begins to divide and enter a period of growth or logarithmic increase
cellular reproduction is most active
generation time reaches a constant minimum
stationary phase
period of equilibrium
microbial deaths balance population of new cells
growth rate slows
population stabilizes
the population exceeds the carrying capacity (number of organisms that an environment can support) and run out of nutrient and space
death phase/logarithmic decline phase
population is decreasing at a logarithmic rate
the number of deaths exceeds the number of new cells being formed
the population is diminished to a tiny fraction of the number of cells or until the population dies out entirely
direct measurement of bacterial growth
serial dilution
counting bacteria by filtration
Petroff-Hausser cell counter
Spectrophotometer